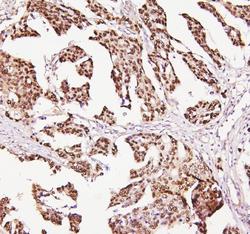

Antibody data
- Antibody Data
- Antigen structure
- References [45]
- Comments [0]
- Validations
- Western blot [1]
Submit
Validation data
Reference
Comment
Report error
- Product number
- PB9008 - Provider product page

- Provider
- Boster Biological Technology
- Product name
- Anti-P53/TP53 Antibody Picoband™
- Antibody type
- Polyclonal
- Description
- Polyclonal antibody for p53/TP53 detection. Host: Rabbit.Size: 100μg/vial. Tested applications: WB, IHC-P, ICC/IF, FCM. Reactive species: Human. p53/TP53 information: Molecular Weight: 43653 MW; Subcellular Localization: Cytoplasm. Nucleus. Nucleus, PML body. Endoplasmic reticulum. Mitochondrion matrix. Interaction with BANP promotes nuclear localization. Recruited into PML bodies together with CHEK2. Translocates to mitochondria upon oxidative stress; Tissue Specificity: Ubiquitous. Isoforms are expressed in a wide range of normal tissues but in a tissue-dependent manner. Isoform 2 is expressed in most normal tissues but is not detected in brain, lung, prostate, muscle, fetal brain, spinal cord and fetal liver. Isoform 3 is expressed in most normal tissues but is not detected in lung, spleen, testis, fetal brain, spinal cord and fetal liver. Isoform 7 is expressed in most normal tissues but is not detected in prostate, uterus, skeletal muscle and breast. Isoform 8 is detected only in colon, bone marrow, testis, fetal brain and intestine. Isoform 9 is expressed in most normal tissues but is not detected in brain, heart, lung, fetal liver, salivary gland, breast or intestine.
- Reactivity
- Human
- Host
- Rabbit
- Vial size
- 100μg/vial
- Concentration
- Add 0.2ml of distilled water will yield a concentration of 500ug/ml.
- Storage
- At -20°C for one year. After reconstitution, at 4°C for one month. It can also be aliquoted and stored frozen at -20°C for a longer time. Avoid repeated freezing and thawing.
- Handling
- Add 0.2ml of distilled water will yield a concentration of 500ug/ml.
Submitted references Involvement of the heat shock response (HSR) regulatory pathway in cadmium-elicited cerebral damage.
Cardioprotection Attributed to Aerobic Exercise-Mediated Inhibition of ALCAT1 and Oxidative Stress-Induced Apoptosis in MI Rats.
Identification of core genes associated with type 2 diabetes mellitus and gastric cancer by bioinformatics analysis.
Punicalagin Attenuates Neuronal Apoptosis by Upregulating 5-Hydroxymethylcytosine in the Diabetic Mouse Brain.
Ferritinophagy-Mediated ROS Production Contributed to Proliferation Inhibition, Apoptosis, and Ferroptosis Induction in Action of Mechanism of 2-Pyridylhydrazone Dithiocarbamate Acetate.
Lipopolysaccharide Affects the Proliferation and Glucose Metabolism of Cervical Cancer Cells Through the FRA1/MDM2/p53 Pathway.
Antitumor effects of dioscin in A431 cells via adjusting ATM/p53-mediated cell apoptosis, DNA damage and migration.
MicroRNA-708 prevents ethanol-induced hepatic lipid accumulation and inflammatory reaction via direct targeting ZEB1.
Chemopreventive Role of Apigenin against the Synergistic Carcinogenesis of Human Papillomavirus and 4-(Methylnitrosamino)-1-(3-pyridyl)-1-butanone.
Detection of p53 mutation and serum monitoring alert caused by Marek's disease virus in poultry.
p53-Mediated PI3K/AKT/mTOR Pathway Played a Role in Ptox(Dpt)-Induced EMT Inhibition in Liver Cancer Cell Lines.
ZWINT is the next potential target for lung cancer therapy.
Combined Phycocyanin and Hematoporphyrin Monomethyl Ether for Breast Cancer Treatment via Photosensitizers Modified Fe(3)O(4) Nanoparticles Inhibiting the Proliferation and Migration of MCF-7 Cells.
Cisatracurium-induced proliferation impairment and death of colorectal cancer cells, HCT116 is mediated by p53 dependent intrinsic apoptotic pathway in vitro.
Antiproliferative and Apoptosis-inducing Effect of exo-Protoporphyrin IX based Sonodynamic Therapy on Human Oral Squamous Cell Carcinoma.
Antitumor Effects of Laminaria Extract Fucoxanthin on Lung Cancer.
Dioscin suppresses hepatocellular carcinoma tumor growth by inducing apoptosis and regulation of TP53, BAX, BCL2 and cleaved CASP3.
A novel polysaccharide from Sargassum integerrimum induces apoptosis in A549 cells and prevents angiogensis in vitro and in vivo.
Fra-1 is upregulated in lung cancer tissues and inhibits the apoptosis of lung cancer cells by the P53 signaling pathway.
Lactotransferrin expression is downregulated and affects the mitogen-activated protein kinase pathway in gastric cancer.
PBK/TOPK expression correlates with mutant p53 and affects patients' prognosis and cell proliferation and viability in lung adenocarcinoma.
Isoflavones extracted from chickpea Cicer arietinum L. sprouts induce mitochondria-dependent apoptosis in human breast cancer cells.
Proteomics analysis of normal and senescent NG108-15 cells: GRP78 plays a negative role in cisplatin-induced senescence in the NG108-15 cell line.
Anti-tumor effect of cactus polysaccharides on lung squamous carcinoma cells (SK-MES-1).
Cisplatin-induced senescence in ovarian cancer cells is mediated by GRP78.
CD38 is highly expressed and affects the PI3K/Akt signaling pathway in cervical cancer.
Nutlin-3 downregulates p53 phosphorylation on serine392 and induces apoptosis in hepatocellular carcinoma cells.
Targeting of histone deacetylases to reactivate tumour suppressor genes and its therapeutic potential in a human cervical cancer xenograft model.
Sulfite exposure-induced hepatocyte death is not associated with alterations in p53 protein expression.
Ran GTPase protein promotes human pancreatic cancer proliferation by deregulating the expression of Survivin and cell cycle proteins.
c-Ski activates cancer-associated fibroblasts to regulate breast cancer cell invasion.
The apoptotic effect and associated signalling of HSP90 inhibitor 17-DMAG in hepatocellular carcinoma cells.
Regression of A549 lung cancer tumors by anti-miR-150 vector.
Decreased levels of nitric oxide production and nitric oxide synthase-2 expression are associated with the development and metastasis of hepatocellular carcinoma.
Silencing MTA1 by RNAi reverses adhesion, migration and invasiveness of cervical cancer cells (SiHa) via altered expression of p53, and E-cadherin/β-catenin complex.
The oncogenic role of NS5A of hepatitis C virus is mediated by up-regulation of survivin gene expression in the hepatocellular cell through p53 and NF-κB pathways.
Downregulation of survivin and activation of caspase-3 through the PI3K/Akt pathway in ursolic acid-induced HepG2 cell apoptosis.
P53 transcription-independent activity mediates selenite-induced acute promyelocytic leukemia NB4 cell apoptosis.
Apoptosis induced by baicalin involving up-regulation of P53 and bax in MCF-7 cells.
Knockdown of survivin and upregulation of p53 gene expression by small interfering RNA induces apoptosis in human gastric carcinoma cell line SGC-823.
Positional and expressive alteration of prohibitin during the induced differentiation of human hepatocarcinoma SMMC-7721 cells.
Fluorescent nanoparticle-based indirect immunofluorescence microscopy for detection of Mycobacterium tuberculosis.
ZNF307, a novel zinc finger gene suppresses p53 and p21 pathway.
Safrole oxide induces apoptosis in A549 human lung cancer cells.
Integrin beta4 mAb inhibited apoptosis induced by deprivation of growth factors in vascular endothelial cells.
Talukder M, Bi SS, Lv MW, Ge J, Zhang C, Li JL
Environmental science and pollution research international 2023 Oct;30(48):106648-106659
Environmental science and pollution research international 2023 Oct;30(48):106648-106659
Cardioprotection Attributed to Aerobic Exercise-Mediated Inhibition of ALCAT1 and Oxidative Stress-Induced Apoptosis in MI Rats.
Liu N, Zhu Y, Song W, Ren W, Tian Z
Biomedicines 2022 Sep 11;10(9)
Biomedicines 2022 Sep 11;10(9)
Identification of core genes associated with type 2 diabetes mellitus and gastric cancer by bioinformatics analysis.
Liu S, Zhao Y, Duan R, Wu Y, Chen X, Li N
Annals of translational medicine 2022 Mar;10(5):247
Annals of translational medicine 2022 Mar;10(5):247
Punicalagin Attenuates Neuronal Apoptosis by Upregulating 5-Hydroxymethylcytosine in the Diabetic Mouse Brain.
He X, Pei S, Meng X, Hua Q, Zhang T, Wang Y, Zhang Z, Zhu X, Liu R, Guo Y, Chen L, Li D
Journal of agricultural and food chemistry 2022 Apr 27;70(16):4995-5004
Journal of agricultural and food chemistry 2022 Apr 27;70(16):4995-5004
Ferritinophagy-Mediated ROS Production Contributed to Proliferation Inhibition, Apoptosis, and Ferroptosis Induction in Action of Mechanism of 2-Pyridylhydrazone Dithiocarbamate Acetate.
Li L, Li H, Li Y, Feng J, Guan D, Zhang Y, Fu Y, Li S, Li C
Oxidative medicine and cellular longevity 2021;2021:5594059
Oxidative medicine and cellular longevity 2021;2021:5594059
Lipopolysaccharide Affects the Proliferation and Glucose Metabolism of Cervical Cancer Cells Through the FRA1/MDM2/p53 Pathway.
Jiang X, Yuan J, Dou Y, Zeng D, Xiao S
International journal of medical sciences 2021;18(4):1030-1038
International journal of medical sciences 2021;18(4):1030-1038
Antitumor effects of dioscin in A431 cells via adjusting ATM/p53-mediated cell apoptosis, DNA damage and migration.
Wang P, Wang C, Liu C
Oncology letters 2021 Jan;21(1):59
Oncology letters 2021 Jan;21(1):59
MicroRNA-708 prevents ethanol-induced hepatic lipid accumulation and inflammatory reaction via direct targeting ZEB1.
Hu S, Liu YM, Chen-Chen, Li LY, Zhang BY, Yang JF, Li HD, Meng XM, Jun-Li, Xu T, Zhou H
Life sciences 2020 Oct 1;258:118147
Life sciences 2020 Oct 1;258:118147
Chemopreventive Role of Apigenin against the Synergistic Carcinogenesis of Human Papillomavirus and 4-(Methylnitrosamino)-1-(3-pyridyl)-1-butanone.
Yin F, Zhao L, Zhang L, Chen Y, Sun G, Li J, Zhang N, Xu Y, Chan PK, Zhong R
Biomedicines 2020 Nov 4;8(11)
Biomedicines 2020 Nov 4;8(11)
Detection of p53 mutation and serum monitoring alert caused by Marek's disease virus in poultry.
Zhang H, Liu M, Zhang H, Cao S, Li Y, Jiang S, Song Y, Liu S
BMC veterinary research 2020 Aug 24;16(1):303
BMC veterinary research 2020 Aug 24;16(1):303
p53-Mediated PI3K/AKT/mTOR Pathway Played a Role in Ptox(Dpt)-Induced EMT Inhibition in Liver Cancer Cell Lines.
Li Y, Wang T, Sun Y, Huang T, Li C, Fu Y, Li Y, Li C
Oxidative medicine and cellular longevity 2019;2019:2531493
Oxidative medicine and cellular longevity 2019;2019:2531493
ZWINT is the next potential target for lung cancer therapy.
Peng F, Li Q, Niu SQ, Shen GP, Luo Y, Chen M, Bao Y
Journal of cancer research and clinical oncology 2019 Mar;145(3):661-673
Journal of cancer research and clinical oncology 2019 Mar;145(3):661-673
Combined Phycocyanin and Hematoporphyrin Monomethyl Ether for Breast Cancer Treatment via Photosensitizers Modified Fe(3)O(4) Nanoparticles Inhibiting the Proliferation and Migration of MCF-7 Cells.
Du SW, Zhang LK, Han K, Chen S, Hu Z, Chen W, Hu K, Yin L, Wu B, Guan YQ
Biomacromolecules 2018 Jan 8;19(1):31-41
Biomacromolecules 2018 Jan 8;19(1):31-41
Cisatracurium-induced proliferation impairment and death of colorectal cancer cells, HCT116 is mediated by p53 dependent intrinsic apoptotic pathway in vitro.
Yabasin IB, Lu Z, Yu JC, Wen Q
Biomedicine & pharmacotherapy = Biomedecine & pharmacotherapie 2017 Jul;91:320-329
Biomedicine & pharmacotherapy = Biomedecine & pharmacotherapie 2017 Jul;91:320-329
Antiproliferative and Apoptosis-inducing Effect of exo-Protoporphyrin IX based Sonodynamic Therapy on Human Oral Squamous Cell Carcinoma.
Lv Y, Zheng J, Zhou Q, Jia L, Wang C, Liu N, Zhao H, Ji H, Li B, Cao W
Scientific reports 2017 Jan 19;7:40967
Scientific reports 2017 Jan 19;7:40967
Antitumor Effects of Laminaria Extract Fucoxanthin on Lung Cancer.
Mei C, Zhou S, Zhu L, Ming J, Zeng F, Xu R
Marine drugs 2017 Feb 15;15(2)
Marine drugs 2017 Feb 15;15(2)
Dioscin suppresses hepatocellular carcinoma tumor growth by inducing apoptosis and regulation of TP53, BAX, BCL2 and cleaved CASP3.
Zhang G, Zeng X, Zhang R, Liu J, Zhang W, Zhao Y, Zhang X, Wu Z, Tan Y, Wu Y, Du B
Phytomedicine : international journal of phytotherapy and phytopharmacology 2016 Nov 15;23(12):1329-1336
Phytomedicine : international journal of phytotherapy and phytopharmacology 2016 Nov 15;23(12):1329-1336
A novel polysaccharide from Sargassum integerrimum induces apoptosis in A549 cells and prevents angiogensis in vitro and in vivo.
Liu G, Kuang S, Wu S, Jin W, Sun C
Scientific reports 2016 May 24;6:26722
Scientific reports 2016 May 24;6:26722
Fra-1 is upregulated in lung cancer tissues and inhibits the apoptosis of lung cancer cells by the P53 signaling pathway.
Zhong G, Chen X, Fang X, Wang D, Xie M, Chen Q
Oncology reports 2016 Jan;35(1):447-53
Oncology reports 2016 Jan;35(1):447-53
Lactotransferrin expression is downregulated and affects the mitogen-activated protein kinase pathway in gastric cancer.
Luo G, Zhou Y, Yi W, Yi H
Oncology letters 2015 May;9(5):2409-2413
Oncology letters 2015 May;9(5):2409-2413
PBK/TOPK expression correlates with mutant p53 and affects patients' prognosis and cell proliferation and viability in lung adenocarcinoma.
Lei B, Qi W, Zhao Y, Li Y, Liu S, Xu X, Zhi C, Wan L, Shen H
Human pathology 2015 Feb;46(2):217-24
Human pathology 2015 Feb;46(2):217-24
Isoflavones extracted from chickpea Cicer arietinum L. sprouts induce mitochondria-dependent apoptosis in human breast cancer cells.
Chen H, Ma HR, Gao YH, Zhang X, Habasi M, Hu R, Aisa HA
Phytotherapy research : PTR 2015 Feb;29(2):210-9
Phytotherapy research : PTR 2015 Feb;29(2):210-9
Proteomics analysis of normal and senescent NG108-15 cells: GRP78 plays a negative role in cisplatin-induced senescence in the NG108-15 cell line.
Li W, Wang W, Li Y, Wang W, Wang T, Li L, Han Z, Wang S, Ma D, Wang H
PloS one 2014;9(3):e90114
PloS one 2014;9(3):e90114
Anti-tumor effect of cactus polysaccharides on lung squamous carcinoma cells (SK-MES-1).
Li W, Wu D, Wei B, Wang S, Sun H, Li X, Zhang F, Zhang C, Xin Y
African journal of traditional, complementary, and alternative medicines : AJTCAM 2014;11(5):99-104
African journal of traditional, complementary, and alternative medicines : AJTCAM 2014;11(5):99-104
Cisplatin-induced senescence in ovarian cancer cells is mediated by GRP78.
Li W, Wang W, Dong H, Li Y, Li L, Han L, Han Z, Wang S, Ma D, Wang H
Oncology reports 2014 Jun;31(6):2525-34
Oncology reports 2014 Jun;31(6):2525-34
CD38 is highly expressed and affects the PI3K/Akt signaling pathway in cervical cancer.
Liao S, Xiao S, Zhu G, Zheng D, He J, Pei Z, Li G, Zhou Y
Oncology reports 2014 Dec;32(6):2703-9
Oncology reports 2014 Dec;32(6):2703-9
Nutlin-3 downregulates p53 phosphorylation on serine392 and induces apoptosis in hepatocellular carcinoma cells.
Shi X, Liu J, Ren L, Mao N, Tan F, Ding N, Yang J, Li M
BMB reports 2014 Apr;47(4):221-6
BMB reports 2014 Apr;47(4):221-6
Targeting of histone deacetylases to reactivate tumour suppressor genes and its therapeutic potential in a human cervical cancer xenograft model.
Feng D, Wu J, Tian Y, Zhou H, Zhou Y, Hu W, Zhao W, Wei H, Ling B, Ma C
PloS one 2013;8(11):e80657
PloS one 2013;8(11):e80657
Sulfite exposure-induced hepatocyte death is not associated with alterations in p53 protein expression.
Bai J, Lei P, Zhang J, Zhao C, Liang R
Toxicology 2013 Oct 4;312:142-8
Toxicology 2013 Oct 4;312:142-8
Ran GTPase protein promotes human pancreatic cancer proliferation by deregulating the expression of Survivin and cell cycle proteins.
Deng L, Lu Y, Zhao X, Sun Y, Shi Y, Fan H, Liu C, Zhou J, Nie Y, Wu K, Fan D, Guo X
Biochemical and biophysical research communications 2013 Oct 18;440(2):322-9
Biochemical and biophysical research communications 2013 Oct 18;440(2):322-9
c-Ski activates cancer-associated fibroblasts to regulate breast cancer cell invasion.
Wang L, Hou Y, Sun Y, Zhao L, Tang X, Hu P, Yang J, Zeng Z, Yang G, Cui X, Liu M
Molecular oncology 2013 Dec;7(6):1116-28
Molecular oncology 2013 Dec;7(6):1116-28
The apoptotic effect and associated signalling of HSP90 inhibitor 17-DMAG in hepatocellular carcinoma cells.
Leng AM, Liu T, Yang J, Cui JF, Li XH, Zhu YN, Xiong T, Zhang G, Chen Y
Cell biology international 2012 Oct 1;36(10):893-9
Cell biology international 2012 Oct 1;36(10):893-9
Regression of A549 lung cancer tumors by anti-miR-150 vector.
Li YJ, Zhang YX, Wang PY, Chi YL, Zhang C, Ma Y, Lv CJ, Xie SY
Oncology reports 2012 Jan;27(1):129-34
Oncology reports 2012 Jan;27(1):129-34
Decreased levels of nitric oxide production and nitric oxide synthase-2 expression are associated with the development and metastasis of hepatocellular carcinoma.
Zhou L, Wang Y, Tian DA, Yang J, Yang YZ
Molecular medicine reports 2012 Dec;6(6):1261-6
Molecular medicine reports 2012 Dec;6(6):1261-6
Silencing MTA1 by RNAi reverses adhesion, migration and invasiveness of cervical cancer cells (SiHa) via altered expression of p53, and E-cadherin/β-catenin complex.
Rao Y, Wang H, Fan L, Chen G
Journal of Huazhong University of Science and Technology. Medical sciences = Hua zhong ke ji da xue xue bao. Yi xue Ying De wen ban = Huazhong keji daxue xuebao. Yixue Yingdewen ban 2011 Feb;31(1):1-9
Journal of Huazhong University of Science and Technology. Medical sciences = Hua zhong ke ji da xue xue bao. Yi xue Ying De wen ban = Huazhong keji daxue xuebao. Yixue Yingdewen ban 2011 Feb;31(1):1-9
The oncogenic role of NS5A of hepatitis C virus is mediated by up-regulation of survivin gene expression in the hepatocellular cell through p53 and NF-κB pathways.
Jiang YF, He B, Li NP, Ma J, Gong GZ, Zhang M
Cell biology international 2011 Dec;35(12):1225-32
Cell biology international 2011 Dec;35(12):1225-32
Downregulation of survivin and activation of caspase-3 through the PI3K/Akt pathway in ursolic acid-induced HepG2 cell apoptosis.
Tang C, Lu YH, Xie JH, Wang F, Zou JN, Yang JS, Xing YY, Xi T
Anti-cancer drugs 2009 Apr;20(4):249-58
Anti-cancer drugs 2009 Apr;20(4):249-58
P53 transcription-independent activity mediates selenite-induced acute promyelocytic leukemia NB4 cell apoptosis.
Guan L, Huang F, Li Z, Han B, Jiang Q, Ren Y, Yang Y, Xu C
BMB reports 2008 Oct 31;41(10):745-50
BMB reports 2008 Oct 31;41(10):745-50
Apoptosis induced by baicalin involving up-regulation of P53 and bax in MCF-7 cells.
Wang N, Tang LJ, Zhu GQ, Peng DY, Wang L, Sun FN, Li QL
Journal of Asian natural products research 2008 Nov-Dec;10(11-12):1129-35
Journal of Asian natural products research 2008 Nov-Dec;10(11-12):1129-35
Knockdown of survivin and upregulation of p53 gene expression by small interfering RNA induces apoptosis in human gastric carcinoma cell line SGC-823.
Lu YH, Wang K, He R, Xi T
Cancer biotherapy & radiopharmaceuticals 2008 Dec;23(6):727-34
Cancer biotherapy & radiopharmaceuticals 2008 Dec;23(6):727-34
Positional and expressive alteration of prohibitin during the induced differentiation of human hepatocarcinoma SMMC-7721 cells.
Xu DH, Tang J, Li QF, Shi SL, Chen XF, Liang Y
World journal of gastroenterology 2008 Aug 28;14(32):5008-14
World journal of gastroenterology 2008 Aug 28;14(32):5008-14
Fluorescent nanoparticle-based indirect immunofluorescence microscopy for detection of Mycobacterium tuberculosis.
Qin D, He X, Wang K, Zhao XJ, Tan W, Chen J
Journal of biomedicine & biotechnology 2007;2007(7):89364
Journal of biomedicine & biotechnology 2007;2007(7):89364
ZNF307, a novel zinc finger gene suppresses p53 and p21 pathway.
Li J, Wang Y, Fan X, Mo X, Wang Z, Li Y, Yin Z, Deng Y, Luo N, Zhu C, Liu M, Ma Q, Ocorr K, Yuan W, Wu X
Biochemical and biophysical research communications 2007 Nov 30;363(4):895-900
Biochemical and biophysical research communications 2007 Nov 30;363(4):895-900
Safrole oxide induces apoptosis in A549 human lung cancer cells.
Du A, Zhang S, Miao J, Zhao B
Experimental lung research 2004 Sep;30(6):419-29
Experimental lung research 2004 Sep;30(6):419-29
Integrin beta4 mAb inhibited apoptosis induced by deprivation of growth factors in vascular endothelial cells.
Zhao KW, Zhao QT, Zhang SL, Miao JY
Acta pharmacologica Sinica 2004 Jun;25(6):733-7
Acta pharmacologica Sinica 2004 Jun;25(6):733-7
No comments: Submit comment
Supportive validation
- Submitted by
- Boster Biological Technology (provider)
- Main image

- Experimental details
- Western blot analysis of P53 using anti-P53 antibody (PB9008). Electrophoresis was performed on a 5-20% SDS-PAGE gel at 70V (Stacking gel) / 90V (Resolving gel) for 2-3 hours. The sample well of each lane was loaded with 50ug of sample under reducing conditions. Lane 1: human CACO-2 whole cell lysates, Lane 2: human HepG2 whole cell lysates, Lane 3: human A431 whole cell lysates. After Electrophoresis, proteins were transferred to a Nitrocellulose membrane at 150mA for 50-90 minutes. Blocked the membrane with 5% Non-fat Milk/ TBS for 1.5 hour at RT. The membrane was incubated with rabbit anti-P53 antigen affinity purified polyclonal antibody (Catalog # PB9008) at 0.5 μg/mL overnight at 4°C, then washed with TBS-0.1%Tween 3 times with 5 minutes each and probed with a goat anti-rabbit IgG-HRP secondary antibody at a dilution of 1:5000 for 1.5 hour at RT. The signal is developed using an Enhanced Chemiluminescent detection (ECL) kit (Catalog # EK1002) with Tanon 5200 system. A specific band was detected for P53 at approximately 53KD. The expected band size for P53 is at 53KD.
- Additional image